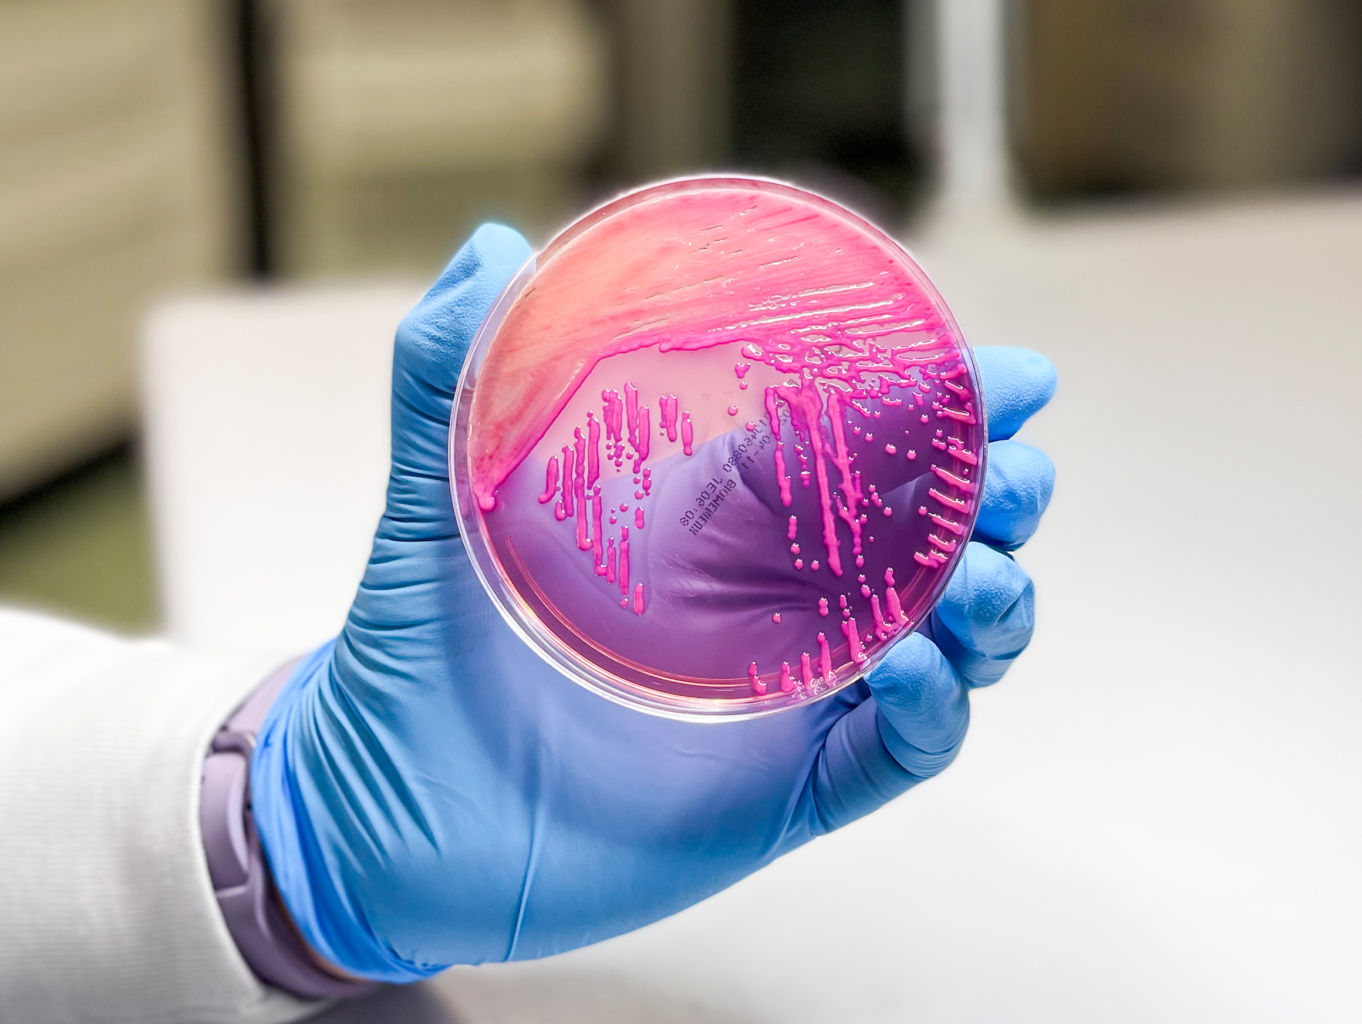

Nuestros Servicios
Servicios de diagnóstico clínico integral


Trabajos de sangre
Platea metus maecenas inceptos tincidunt finibus facilisi consequat magnis dictumst.

Microbiología
Ornare adipiscing felis in potenti netus torquent scelerisque euismod tempor per curae.

Alimentos
In vivamus auctor quisque bibendum sociosqu interdum sapien faucibus duis proin tempus.

Exámenes ADN
Mauris aliquet integer proin tortor cubilia fringilla augue praesent ullamcorper placerat.

Hematológicos
Los exámenes hematológicos evalúan la calidad y cantidad de los componentes de la sangre, como glóbulos rojos, glóbulos blancos y plaquetas. Permiten diagnosticar anemias, infecciones, trastornos de la médula ósea y otras enfermedades hematológicas.
Ejemplo: Hemograma completo, frotis de sangre periférica.

Coagulación
Las pruebas de coagulación analizan la capacidad de la sangre para formar coágulos correctamente y detectar trastornos hemorrágicos o trombóticos. Son esenciales para el monitoreo de tratamientos anticoagulantes y en cirugías.
Ejemplo: TP (Tiempo de Protrombina), TTP (Tiempo de Tromboplastina Parcial), INR

Química Clínica y Enzimas
Los exámenes de química clínica y enzimas son esenciales para evaluar el estado general de salud y detectar alteraciones en el funcionamiento de órganos vitales como el hígado, riñones, corazón, páncreas, etc.
Ejemplos de pruebas: Glucosa, ALT (TGP), AST (TGO), creatinina, ácido úrico, colesterol, triglicéridos.

Electrolitos
Los electrolitos son minerales presentes en la sangre que regulan funciones vitales como el equilibrio hídrico, la función muscular y nerviosa, y el mantenimiento del pH corporal. Las pruebas de electrolitos ayudan a detectar desequilibrios asociados a deshidratación, insuficiencia renal, trastornos cardíacos o metabólicos.
Ejemplos de electrolitos: Sodio, potasio, cloro, calcio, magnesio.

Marcadores Oncologicos
Los marcadores oncológicos son sustancias, generalmente proteínas, que se encuentran en la sangre, orina o tejidos corporales. Su presencia o niveles elevados pueden indicar el desarrollo de ciertos tipos de cáncer o ayudar a monitorear la evolución de la enfermedad y la efectividad del tratamiento.
Ejemplos:
- PSA (Antígeno Prostático Específico)
- CEA (Antígeno Carcinoembrionario)
- CEA (Antígeno Carcinoembrionario).
- AFP (Alfafetoproteína)
- CA 125
- CA 19-9

Hormonas
Miden los niveles de hormonas en sangre para evaluar el funcionamiento del sistema endocrino. Son esenciales en el diagnóstico de trastornos relacionados con el metabolismo, la reproducción, el crecimiento y el equilibrio hormonal general
Ejemplos
TSH, fT3, Ft4, FSH, LH, PROLACTINA, INSULINA, etc

Inmunologicos
Los exámenes inmunológicos evalúan la respuesta del sistema inmunitario y detectan la presencia de anticuerpos, antígenos o marcadores inflamatorios. Son fundamentales para el diagnóstico de enfermedades infecciosas, autoinmunes, alérgicas y el monitoreo del estado inmunológico general.
Ejemplos
- ANA (Anticuerpos Antinucleares)
- Toxoplasmosis IgG/IgM
- PCR (Proteína C Reactiva)
- Inmunoglobulina E (IgE)
- Hepatitis (B y C)

Orina
Los exámenes de orina evalúan componentes químicos, físicos y microscópicos de la orina para diagnosticar infecciones, trastornos renales, metabólicos y urinarios.
Ejemplos
- EMO (Elemental y microscópico de Orina)
- Urocultivo
- Microalbuminuria
- Prueba de embarazo

Heces
Los exámenes de heces identifican parásitos, infecciones, trastornos digestivos o problemas metabólicos, analizando componentes físicos, químicos y microbiológicos.
Ejemplos
- Coprológico y coproparasitario
- Cultivo de heces
- Prueba de sangre oculta
- Helicobacter pylori Antígeno
- Rotavirus

Microbiológicos
Los exámenes microbiológicos identifican microorganismos como bacterias, virus, hongos y parásitos responsables de infecciones en diferentes partes del cuerpo. Estas pruebas son fundamentales para el diagnóstico preciso y el tratamiento adecuado de enfermedades infecciosas
Ejemplos
- Urocultivo
- Hemocultivo
- Cultivo micológico
- KOH directo
- Antibiograma
Biología Molecular
Los exámenes de biología molecular detectan y analizan material genético (ADN y ARN) de microorganismos o del paciente, utilizando técnicas avanzadas para el diagnóstico temprano, seguimiento y pronóstico de enfermedades infecciosas, genéticas y oncológicas.
Ejemplos
- PCR (Reacción en Cadena de la Polimerasa)
- Paneles genéticos para cáncer
- Detección de translocaciones
- Pruebas de detección de mutaciones genéticas
- Pruebas de paternidad

Varios
En la categoría de varios, se incluyen exámenes complementarios que no encajan exclusivamente en una sola área, pero que son fundamentales para el diagnóstico integral y la evaluación de la salud del paciente.
Ejemplos
- Pruebas toxicológicas
- Vitaminas y minerales
- Espermatograma